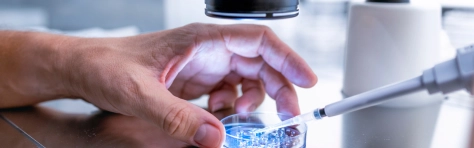

Étude | Risque de transition
Mai 2026 | Analyse du risque de transition climatique et de ses impacts sur les spreads, les probabilités de défaut et la valorisation des obligations corporate, avec une lecture sectorielle différenciée.

Mai 2026 | Analyse du risque de transition climatique et de ses impacts sur les spreads, les probabilités de défaut et la valorisation des obligations corporate, avec une lecture sectorielle différenciée.

Mai 2026 | Focus sur les impacts du règlement relatif à la prévention de l’utilisation du système financier aux fins du BC-FT « AMLR »

Découvrez le Baromètre C-Level 2026 Énergie & Infrastructures de Forvis Mazars, une analyse approfondie des priorités stratégiques et des perspectives de croissance du secteur. Basée sur les retours de plus de 3 000 dirigeants à l’échelle mondiale, cette étude met en lumière les grands enjeux qui façonnent l’industrie : transformation technologique, impact de l’intelligence artificielle, tensions...

Avril 2026 | Pour la cinquième année consécutive, Forvis Mazars, en partenariat avec l’Institut Montaigne, est associé à la publication du Baromètre européen des impôts de production. Cette édition 2026 compare le niveau et l’évolution des impôts de production dans 14 pays européens.

Avril 2026 | Pour répondre aux défis posés par le réchauffement climatique, les entreprises sont invitées à évaluer leurs émissions de gaz à effet de serre, élaborer des plans de transition crédibles assortis de moyens, analyser leurs expositions aux risques climatiques - physiques et de transition -, en évaluer les impacts financiers, et développer des politiques d’adaptation appropriées.

Mars 2026 | Forvis Mazars et France FinTech publient le baromètre de référence du crowdfunding en France.

Mars 2026 | Forvis Mazars a mené cette étude pour décrypter les opportunités, les risques et les conditions de réussite de l’intelligence artificielle dans le secteur médico-social. À travers analyses terrain, cas d’usage et éclairages réglementaires (RGPD, AI Act), découvrez comment structurer un déploiement éthique, sécurisé et créateur de valeur.

Février 2026 | L’intelligence artificielle s’impose dans tous les métiers. Elle optimise les décisions, automatise les processus, personnalise l’expérience client et accélère les analyses. Mais une réalité plus silencieuse se cache derrière cette transformation.

Forvis Mazars publie la 6ᵉ édition de son Baromètre C-Level, une étude menée auprès de plus de 3 000 dirigeants dans le monde. Cette édition 2026 révèle un paradoxe : une incertitude économique persistante, mais aussi un fort potentiel de croissance pour les organisations capables d’innover, d’investir et de s’adapter rapidement. Les entreprises les plus performantes sont celles qui anticipent :...

Janvier 2026 | Forvis Mazars en France en collaboration avec l’ ASPIM, a mené une étude comparative approfondie sur les indicateurs clés de performance, de risques et de stratégies suivies par les FIA immobiliers « grand public » (SCPI, OPCI, SC). Cette analyse annuelle, qui examine les documents publiés en 2025 de 56 sociétés de gestion de portefeuille immobilières, vise principalement à identifier,...

Décembre 2025 | Découvrez en exclusivité le premier benchmark réalisé par les équipes de Forvis Mazars, présentant un panorama des outils dédiés à la production des reportings du Pilier 3 de Solvabilité II en France.

Décembre 2025 | Découvrez la deuxième édition du Baromètre des salaires en trésorerie, publié par l’AFTE, Forvis Mazars et Mercer.

Novembre 2025 | Découvrez les résultats du Baromètre M&A 2025 réalisé par Forvis Mazars et l’ARFA auprès des directions M&A de grandes entreprises françaises. Une analyse exclusive sur l’organisation, les moyens, les outils et les rémunérations du métier.

Octobre 2025 | La troisième édition de l’étude menée par Forvis Mazars sur les enjeux de durabilité dans les états financiers porte sur l’exercice 2024, marqué par la première publication des états ESRS. Ce contexte ne semble ni avoir enlevé de matière aux annexes, ni en avoir indûment rajouté. L’information sur les enjeux de durabilité est désormais bien installée, organisée et généralisée dans les...

Octobre 2025 | Face aux bouleversements engendrés par la pandémie, les tensions géopolitiques et l’urgence climatique, la relocalisation de l’industrie de la santé en Europe s’impose comme un impératif stratégique. Avec cette nouvelle étude, Forvis Mazars propose un décryptage des leviers et des freins auxquels font face les acteurs du secteur pour construire une chaîne de valeur pharmaceutique et...

Septembre 2025 | Forvis Mazars et France FinTech publient le baromètre semestriel du crowdfunding en France. Ce baromètre fait état du dynamisme d'un secteur au service d'une économie de proximité et de projets qui font sens.

Septembre 2025 | Forvis Mazars publie la 15ème édition de son Baromètre RSE, une étude de référence qui décrypte les premiers états de durabilité publiés par les grandes entreprises européennes conformément aux normes ESRS. Dans un contexte marqué par la publication du paquet « Omnibus » et de la directive « Stop the Clock », cette édition propose une lecture exclusive des premiers enseignements...

Juillet 2025 | La Directive sur la publication d’informations en matière de durabilité des entreprises (Corporate Sustainability Reporting Directive ou « CSRD ») est une réglementation de l’Union européenne visant à renforcer la transparence et la responsabilité des entreprises sur les enjeux de durabilité. Entrée en vigueur le 1er janvier 2024, la CSRD impose aux entreprises concernées par la «...

Juillet 2025 | La Directive sur la publication d’informations en matière de durabilité des entreprises (Corporate Sustainability Reporting Directive ou « CSRD ») impose aux grandes entreprises européennes de publier, dès 2025, un état de durabilité au titre de l’exercice 2024. Cette obligation s’appuie sur les normes européennes de reporting de durabilité (ESRS), qui couvrent l’ensemble des enjeux...

Juillet 2025 | La Directive sur la publication d’informations en matière de durabilité des entreprises (Corporate Sustainability Reporting Directive ou « CSRD ») est une réglementation de l’Union européenne visant à renforcer la transparence et la responsabilité des entreprises sur les enjeux de durabilité. Entrée en vigueur le 1er janvier 2024, la CSRD impose aux entreprises de présenter des informations...

Juillet 2025 | Entrée en vigueur le 1er janvier 2024, la CSRD impose aux entreprises de présenter des informations détaillées liés à ses impacts, risques et opportunités matériels en ce qui concerne les enjeux de durabilité dans les domaines environnementaux, sociaux et de gouvernance (ESG).

Juillet 2025 | Face à l'instabilité économique, Forvis Mazars, Sidetrade et Creditsafe analysent comment les entreprises adaptent leurs pratiques de trésorerie et renforcent leur agilité financière.

Juillet 2025 | 60 ans après la loi du 13 juillet 1965 qui a marqué un tournant dans l’autonomie économique des femmes, Forvis Mazars et Financi’Elles publient une étude inédite sur l’émancipation financière des Françaises. Réalisée en collaboration avec CSA Research, cette enquête révèle une réalité contrastée : si les femmes s’emparent de plus en plus des outils de leur indépendance, des inégalités...

Septembre 2025 | Dans un contexte économique national marqué par l’incertitude, la Bretagne se distingue par la solidité de son tissu entrepreneurial. Le Baromètre 2025 sur le moral des dirigeants bretons, réalisé par Forvis Mazars avec l'insitut CSA Research en partenariat avec le Forum Économique Breton, révèle une région à la fois confiante dans ses forces et lucide face aux défis à venir.

Juillet 2025 | La Directive sur la publication d’informations en matière de durabilité des entreprises (Corporate Sustainability Reporting Directive ou « CSRD ») est une réglementation de l’Union européenne visant à renforcer la transparence et la responsabilité des entreprises sur les enjeux de durabilité. Entrée en vigueur le 1er janvier 2024, la CSRD impose aux entreprises concernées par la «...

Juillet 2025 | La Directive sur la publication d’informations en matière de durabilité des entreprises (Corporate Sustainability Reporting Directive ou « CSRD ») est une réglementation de l’Union européenne visant à renforcer la transparence et la responsabilité des entreprises sur les enjeux de durabilité. Entrée en vigueur le 1er janvier 2024, la CSRD impose aux entreprises concernées par la «...

Juillet 2025 | Après une nouvelle année de croissance rentable en 2024, comment les majors européens abordent une année 2025 marquée par une incertitude géopolitique mondiale ? Focus Sustainability : quels leviers les majors européens ont-ils activés pour tenir leurs trajectoires de décarbonation d’ici 5 ans ?

En 2019, Forvis Mazars publiait la première édition de son baromètre « Les Français et la transformation des services publics » en partenariat avec Opinion Way. Cette étude révélait une relation ambivalente entre les citoyens et leurs services publics : attachement fort à la proximité, reconnaissance des efforts de modernisation… mais aussi de vives inquiétudes face à la dématérialisation croissante. Six...

Juin 2025 | La Directive sur la publication d’informations en matière de durabilité des entreprises (Corporate Sustainability Reporting Directive ou « CSRD ») est une réglementation de l’Union européenne visant à renforcer la transparence et la responsabilité des entreprises sur les enjeux de durabilité. Entrée en vigueur le 1er janvier 2024, la CSRD impose aux entreprises concernées par la « vague...

La Directive sur la publication d’informations en matière de durabilité des entreprises (Corporate Sustainability Reporting Directive ou « CSRD ») est une réglementation de l’Union européenne visant à renforcer la transparence et la responsabilité des entreprises sur les enjeux de durabilité. Entrée en vigueur le 1er janvier 2024, la CSRD impose aux entreprises concernées par la « vague 1 » de publier,...

Juin 2025 | La Directive sur la publication d’informations en matière de durabilité des entreprises (Corporate Sustainability Reporting Directive ou « CSRD ») est une réglementation de l’Union européenne visant à renforcer la transparence et la responsabilité des entreprises sur les enjeux de durabilité. Entrée en vigueur le 1er janvier 2024, la CSRD impose aux entreprises concernées par la « vague...

Juin 2025 | Découvrez notre benchmark Euro Stoxx 50 et CAC 40 sur les nouvelles obligations d’information en IFRS à partir de 2024 liées au Reverse Factoring (Supplier Finance Arrangements).

Juin 2025 | Analyse des rapports SFCR 2024 : solvabilité, gouvernance et performance de 20 assureurs français face aux défis économiques et réglementaires.

Juin 2025 | Autrefois perçues comme abondantes, les matières premières sont aujourd’hui au cœur de tensions économiques, géopolitiques et environnementales. Le secteur immobilier, grand consommateur de ressources comme le sable, le cuivre ou les terres rares, se retrouve confronté à des risques inédits : raréfaction, instabilité des marchés, dépendance accrue. Dans ce contexte incertain, une question...

Juin 2025 | Alors que l'année écoulée a été marquée par l'incertitude à l'échelle mondiale, l'évolution des réglementations et le rythme effréné de l'innovation, les dirigeants du secteur Services financiers redéfinissent leurs priorités stratégiques. S'appuyant sur les observations de C-Levels issus de plus de 35 pays, notre dernier rapport décrit comment les acteurs du secteur font face à la complexité,...

Juin 2025 | Forvis Mazars publie son étude annuelle sur l’application de la norme IFRS 17 par un panel international de 23 assureurs et réassureurs. Cette édition 2025 offre une analyse approfondie des communications financières au 31 décembre 2024, couvrant : Les indicateurs clés de performance (CSM, ratio combiné, PVNBP, ROE, etc.) ; les données quantitatives issues des états financiers consolidés...

Mai 2025 | Face à l’urgence d’innover et à la fragmentation des financements, la collaboration entre grandes entreprises et startups est plus stratégique que jamais. Pourtant, les différences de rythme, de culture et de langage freinent encore trop souvent ces alliances. Forvis Mazars dévoile une étude exclusive qui décrypte les blocages, identifie les leviers d’un partenariat réussi, et propose des...

Mai 2025 | La transparence des honoraires d’audit est essentielle pour instaurer la confiance entre les investisseurs, les entités, les autorités de régulation et l’ensemble des parties prenantes. Elle permet de prendre des décisions informées et d’améliorer l’efficacité du marché, dans l’intérêt de tous. Il est essentiel de garantir un marché de l’audit équitable et concurrentiel, fondé sur la qualité.

Mai 2025 | La donnée est devenue un actif stratégique. Pourtant, sa gouvernance reste trop souvent mal comprise, sous-exploitée ou mal intégrée à la culture d’entreprise. Découvrez comment mettre en place une gouvernance data performante, soutenue par une organisation claire, des outils adaptés et des cas d’usage à fort impact.

Avril 2025 | Comment les entreprises du CAC 40 et de l’Euro Stoxx 50 communiquent-elles sur leurs Corporate Power Purchase Agreements et Virtual Power Purchase Agreements ? Découvrez en exclusivité le benchmark réalisé par Forvis Mazars qui décrypte la communication dans les états financiers liée aux contrats d’achat d’énergie à long terme.

Avril 2025 | Cette étude Forvis Mazars décrypte les sanctions ACPR de 2021 à 2024 : tendances, thématiques récurrentes, griefs LCB-FT, évolution du contrôle interne, supervision des crypto-actifs avec MiCA et AMLA. Un indispensable pour les professionnels de la conformité bancaire, assurantielle et crypto.

Avril 2025 | Pour la quatrième année consécutive, Forvis Mazars a mis en commun les compétences de ses experts en fiscalité (Forvis Mazars Avocats) avec celles des équipes de l’Institut Montaigne pour élaborer un comparatif inédit du niveau des impôts de production dans plusieurs pays européens.

Février 2025 | Forvis Mazars dévoile la 5ᵉ édition de son Baromètre C-Level, une étude d’envergure mondiale qui donne la parole à plus de 1 700 dirigeants de plus de 35 pays. Cette enquête, menée auprès de décideurs clés de grandes entreprises, explore les priorités stratégiques, les défis et les leviers de transformation des entreprises. En France, une cinquantaine de dirigeants ont été interrogés....
Mai 2025 | Alors que l'année écoulée a été marquée par l'incertitude à l'échelle mondiale, l'évolution des réglementations et le rythme effréné de l'innovation, les dirigeants du secteur Life Sciences & Pharma redéfinissent leurs priorités stratégiques. S'appuyant sur les observations de C-Levels issus de plus de 35 pays, notre dernier rapport décrit comment les acteurs du secteur font face à la complexité,...

Février 2025 | Découvrez en exclusivité le premier benchmark des outils TMS utilisés par les ETI françaises réalisé par l'AFTE et Forvis Mazars.

Février 2025 | Le crowdfunding énergies renouvelables (EnR) accuse un léger retrait (-4,3 %) mais renforce sa position de deuxième secteur derrière l’immobilier

Février 2025 | Le crowdfunding immobilier enregistre un net repli (-25,8 %) mais demeure le premier secteur en termes de volume de collecte

Février 2025 | Forvis Mazars et France FinTech publient le baromètre de référence du crowdfunding en France.

Janvier 2025 | Ce rapport présente les conclusions de l’enquête mondiale sur le Private Equity menée par Forvis Mazars, regroupant les perspectives de plus de 300 répondants provenant d’Amérique du Nord, d’Europe, d’Asie-Pacifique, d’Afrique et d’Amérique latine.

Janvier 2025 | Depuis deux ans, les gestionnaires de FIA immobiliers sont confrontés à des défis croissants : une forte augmentation des taux d'intérêts depuis 2022, une diminution des volumes de collecte pour les FIA immobiliers « grand public », une baisse des valorisations des immeubles, notamment pour les bureaux en zones périphériques, une pression sur la liquidité de certains fonds, et l'atteinte...

Au lendemain du plus grand salon technologique au monde, Forvis Mazars vous propose un décryptage complet des tendances de l'édition 2025 du CES. Cette analyse pousse aussi à la réflexion sur les grands enjeux actuels et leur représentation lors de ce salon.

Octobre 2024 | Découvrez le benchmark 2024 des systèmes de gestion de trésorerie (TMS), une analyse approfondie des tendances actuelles et des attentes des entreprises françaises basée sur proche de 80 interviews d’utilisateurs et d’éditeurs.

Octobre 2024 | Le 9 avril 2024, l’International Accounting Standard Board (IASB) achevait ses travaux visant à améliorer la qualité de l’information financière et publiait la nouvelle norme IFRS 18 « Présentation et informations à fournir dans les états financiers ».

Octobre 2024 | Diversité, équité et inclusion. Effet de mode ou véritable enjeu dans le monde de l’investissement en capital risque ? Cette étude indépendante se distingue par l'analyse de 37 des fonds d’investissement français les plus actifs en early stage et de leurs portfolios de startups, et la mesure de leur niveau de diversité et d’inclusion en termes de genre, de génération et de formation....

Septembre 2024 | L’année 2023 se termine avec un montant d’investissement de 12 milliards d’euros, en baisse de 60% par rapport à 2022, mais avec des différences marquées selon les classes d’actifs. Les bureaux restent la catégorie d’actifs privilégiée des investisseurs mais ne représentent plus que 53% des volumes, confirmant la tendance débutée sur 2022, en raison de la hausse des taux et les...

Septembre 2024 | Forvis Mazars et l'AFTE dévoilent avec fierté le premier baromètre des salaires de la trésorerie en France, une initiative pionnière qui cartographie les rémunérations au sein des départements de financement et trésorerie. Cette étude, enrichie par les contributions de plus de 350 professionnels, jette un éclairage inédit sur les facteurs clés influençant la rémunération et la progression...

Septembre 2024 | Forvis Mazars et France FinTech publient le baromètre semestriel du crowdfunding en France. Ce baromètre fait état du dynamisme d'un secteur au service d'une économie de proximité et de projets qui font sens.

Septembre 2024 | Forvis Mazars publie son 14ème baromètre RSE qui analyse le contenu des rapports extra-financiers de sociétés cotées. Un an avant le premier exercice d'application de la CSRD (publication en 2025 sur l’exercice 2024), le baromètre se concentre sur l’anticipation de la mise en œuvre de cette nouvelle réglementation afin de tenter d’apprécier le niveau d’avancement des entreprises dans...

Juillet 2024 | Pour la 3e année consécutive, les majors européens enregistrent une hausse significative de leur activité et parviennent à atteindre un taux de marge d’avant crise Covid. Et cela dans un contexte économique et géopolitique globalement incertain. Dans le cadre de la 3e publication de la Taxonomie, une tendance positive de la part croissance de l’activité éligible et alignée est également...

Juillet 2024 | Les directeurs administratifs et financiers (DAF) assument un rôle aussi complexe que central dans la gestion financière et le pilotage stratégique des entreprises. Ce double défi doit aujourd’hui être relevé dans un contexte économique et réglementaire en perpétuelle évolution, caractérisé par la nécessité pour les organisations de parvenir à s’adapter et à innover pour rester compétitives....

En France, le secteur de l’immobilier reste l'un des plus gros émetteurs de gaz à effet de serre, avec 23 % de l’empreinte carbone totale du pays et 43 % de sa consommation énergétique globale, selon le Ministère de la transition écologique. Ce secteur se place en deuxième position après les transports.

Juillet 2024 | L'année 2023, par son actualité tant économique que géopolitique, s'est inscrite dans le sillage de 2022. Malgré une décélération de l’inflation, les taux d’intérêt ont connu une évolution contrastée, avec une hausse au cours des neuf premiers mois, suivie d’une forte baisse au dernier trimestre. Cette volatilité a également affecté le marché du crédit, tandis que les marchés boursiers...

Juin 2024 | L’institut de recherche « AI for Sustainability » de l’ESSCA School of Management et Forvis Mazars publient aujourd’hui les conclusions de leur 1er baromètre dédié à l’intégration de l’Intelligence Artificielle (IA) dans les entreprises européennes et son lien avec la durabilité. 400 responsables informatiques en France et au Royaume-Uni ont été interrogés pour cette étude qui explore...

Juin 2024 | Le secteur du marketing a toujours été un secteur très ouvert aux nouvelles pratiques et les technologies émergentes y ont leur place. Les métiers éprouvent des difficultés à concevoir une stratégie marketing efficace pour leur entreprise. La bonne nouvelle est que le Big Data ouvre de nombreuses portes pour améliorer ces stratégies. Par le biais de plusieurs logiciels, les compagnies...

Le 18 octobre 2022, Vallée Sud – Grand Paris a reçu le président du groupe DataValue Consulting part of Mazars, Abdelaziz Joudar, à l’occasion d’une table ronde dédiée à l’IA. Celui-ci est intervenu aux cotés de Laurence Fornari, cofondatrice et directrice des opérations chez Phedone, startup spécialisée dans le traitement automatique du langage et l’analyse des retours client augmentées par l’IA....

Juin 2024 | 82% des entreprises questionnées dans le cadre du baromètre « Les priorités data des décideurs en 2023 » affirment avoir mis moins de 5 cas d’usage en production jusqu’à présent, 23% affirment n’en avoir déployé aucun. Comment définir les cas d’usage data ? Comment les industrialiser pour assurer un retour sur investissement de la stratégie data ?

Juin 2024 | Les données de santé offrent de larges perspectives d’innovation et de progrès pour le secteur. La crise de la COVID-19 a mis en lumière la valeur que recèlent ces données et leur utilité à des fins d’analyse, d’information et de sensibilisation.

La crise Covid-19 et ses bouleversements ont jeté un voile d’incertitude sur les meilleures stratégies de pilotage immobilier à adopter. Second poste de dépense des entreprises après la masse salariale, la gestion du parc immobilier ne peut se concevoir sans une veille et une adaptation permanente. A moins de disposer d’un responsable de parc immobilier au sein d’une organisation, cette tâche incombe...

Pour réussir la mise en production des cas d’usage data, définis lors de la phase de cadrage, les entreprises doivent choisir et implémenter une plateforme data basée sur une architecture adaptée à leurs besoins et leurs contraintes.

D’après le baromètre annuel sur « Les priorités data des décideurs en 2023 », 56% des organisations interrogées envisagent de mettre en place un framework de gouvernance des données (organisation, processus, standards, comitologie) au sein de leur organisation en 2023. Alors comment assurer une traçabilité transverse au sein de votre organisation ? Quelles sont les mesures-clés pour une démarche de...

Lors de la réalisation du baromètre des priorités data 2022, nous avons eu l’occasion de questionner des décideurs sur leur stratégie data. Il s’avère que la moitié d’entre eux n’ont pas de stratégie data claire et partagée. Cela se traduit par une certaine lenteur dans l’exécution de la feuille de route data et par l’apparition de surcoûts. La cause de ces difficultés ? Un manque de coordination...

Mai 2024 | Dans un monde en constante évolution technologique, la modernisation des systèmes d'information (SI) est cruciale pour la compétitivité des entreprises.

Mai 2024 | Les assureurs et réassureurs publient pour la première fois leurs états financiers annuels établis selon les principes de la norme IFRS 17.

Mai 2024 | En analysant plus de 1700 profils de startups, de plus de 100 pays, l'étude plonge dans l'univers de l'entreprenariat et identifie les défis les plus pressants auxquels font face ces entreprises pas comme les autres. Cette analyse étendue, intitulée "Quel est leur facteur X ? Les 3 leviers de succès (ou d'échec) des startups en 2024" offre un aperçu précieux aux entrepreneurs, investisseurs...

Le baromètre annuel C-level 2024 recueille les points de vue de dirigeants du monde entier pour obtenir grâce à leurs réponses les priorités stratégiques à l'ordre du jour des dirigeants, ainsi que les tendances du marché et les transformations qui devraient avoir un impact sur les entreprises dans les années à venir. Cette dernière étude révèle que 2024 devrait être une année de rebond : une année...

Mars 2024 | 300 milliards d’euros d’ici 2050, c'est le coût de l’adaptation au changement climatique pour la France. Les COP et les engagements des États et des entreprises se succèdent mais faute d’actions à la hauteur de la crise climatique, nous avons déjà dépassé tous les seuils de réchauffement fixés dans l’Accord de Paris. Dans son nouvel ouvrage, Maximilien Rouer modélise pour la première fois...

Février 2024 | La France a fait part de sa volonté d’adopter de nouvelles mesures pour renforcer son attractivité. Si elle compte le faire notamment sur le volet financier auprès des investisseurs étrangers, elle doit aussi soutenir l’attractivité de son industrie. Le poids des impôts de production, qui touche particulièrement ce secteur, reste très élevé en France et demeure un réel enjeu de compétitivité.

La simple exploitation d’une idée brillante ou d’une technologie innovante ne suffit plus. Dans le contexte actuel, les entrepreneurs du secteur techno sont confrontés à une multitude de défis qui dépassent le simple cadre de l’innovation. Ils nécessitent un plan d’affaires robuste, une stratégie bien définie et une adéquation produit-marché solide.

Février 2024 | Le crowdfunding énergies renouvelables (EnR) enregistre une nouvelle progression (+11,5 %) et se positionne comme le deuxième secteur derrière l’immobilier

Février 2024 | Après une décennie de collecte exceptionnelle, dans un contexte de remontée brutale des taux d’intérêt et consécutivement au changement de cycle sur les valorisations des immeubles, de plus en plus de FIA immobiliers « grand public » doivent faire face à des demandes de rachats ou de retraits dans des volumes inhabituels et à une attention renforcée sur leur liquidité. Mazars en collaboration...

Février 2024 | Le crowdfunding immobilier enregistre un net repli (-28 %) mais demeure le premier secteur en termes de volume de collecte

Février 2024 | Pour la 5ème année consécutive, Mazars et l’association Financement Participatif France (FPF) publient le baromètre de référence du crowdfunding en France. Ce baromètre fait état du dynamisme d'un secteur au service d'une économie de proximité et de projets qui font sens.

Février 2024 | Les années 2021 et 2022 ont été marquées par des fluctuations records des prix du gaz et de l’électricité. Cette volatilité inédite a eu des répercussions majeures sur la rentabilité et la trésorerie d’entreprises de tous secteurs. La gestion de cette volatilité des prix de l’énergie devient dorénavant une problématique stratégique de premier plan pour les dirigeants.

Janvier 2024 | Nous avons interrogé directement 43 sociétés de capital-investissement de 8 pays européens différents (avec l'aide de l'institut de sondage CSA en France) et recueilli des informations auprès de 141 sociétés par le biais d'un questionnaire en ligne distribué avec le soutien d'ARX.

Janvier 2024 | Après une première édition portant sur les comptes 2021 qui avait révélé l’intérêt des entreprises pour les enjeux climatiques, notre seconde étude, sur les comptes 2022, montre une généralisation et un enrichissement de l’information. Cette étude porte sur l'intégralité des entreprises du CAC 40 et de l'Euro Stoxx 50.

L’IFA publie un rapport intitulé « Durabilité : les nouveaux engagements du conseil » sur les nouvelles exigences en matière d'informations de durabilité et les incidences pour l’administrateur dans le cadre de ses missions. Carole Masson et Edwige Rey, associées Mazars, ont contribué à ce guide dans le cadre de leur participation au groupe de travail reporting extra-financier de l’IFA.

Novembre 2023 | Face aux tensions géopolitiques au Proche-Orient et en Ukraine, à la pandémie de COVID-19 et aux évolutions sociales à l’œuvre, les entreprises doivent s’adapter et, autant que possible, anticiper ces événements. Cette incertitude impacte fortement la fonction Finance, qui est à l’intersection de nombreux processus de l’entreprise, et lui impose une prise de mesures rapide.

Septembre 2023 | En pleine transition ESG, le secteur de la consommation fait face à des exigences contradictoires. A la fois consommateurs et citoyens, les acheteurs essaient de combiner acte d’achat et acte responsable : un paradoxe auquel le secteur doit aujourd’hui répondre. La présente étude menée au niveau mondial, a pour objectif de fournir un décryptage concret sur la manière dont les entreprises...

Novembre 2023 | Mazars et Estimeo publient la troisième édition du Baromètre de Confiance des Startups en France et révèlent l'état de l'Indice de Confiance des Dirigeants de Startups en ce deuxième semestre de 2023.

Novembre 2023 | Depuis le 2 août 2022, les banques sont assujetties à de nouvelles obligations en matière de durabilité : la prise en compte des préférences des clients en investissement durable. Ces obligations s’inscrivent dans leurs exigences organisationnelles et sont applicables dans le cadre de la fourniture de services de conseil en investissement ou de gestion de portefeuille.

Novembre 2023 | L’Autorité de contrôle prudentiel et de résolution (ACPR) veille au respect par les entités soumises à son contrôle, des obligations en matière de Lutte contre le blanchiment de capitaux et le financement du terrorisme (LCB-FT).

Octobre 2023 | L’année 2022 s’annonçait inédite compte tenu d’une pression inflationniste grandissante, de pénuries et hausses de coûts de l’énergie et des matières premières de plus en plus marquées. Avec 17% de croissance, 2022 aura finalement été une année record pour tous les majors du secteur, en France comme en Europe : du jamais vu depuis 12 ans !

Novembre 2023 | Dans un contexte boursier incertain, avec des levées de fonds qui s’inscrivent en fort déclin par rapport aux années précédentes, les HealthTechs cotées font face à des enjeux majeurs en matière de communication financière. Face à cet environnement de marché particulièrement éprouvant pour les émetteurs, ces derniers se doivent de maintenir un haut niveau d’exigence et d’exemplarité...

Octobre 2023 | Dans un monde devenu dépendant de la technologie numérique, les stratégies de cybersécurité actuelles de la plupart des organisations ne suffisent plus à lutter contre les menaces. Préparez l'avenir de votre entreprise en comprenant et en atténuant les cyber-risques.

Octobre 2023 | Infléchir le comportement des contribuables afin de favoriser la transition écologique et climatique, tels sont les objectifs de la France et de l’Europe dans la perspective d’atteindre la neutralité carbone en 2050. Cette ambition se traduit par un arsenal réglementaire et fiscal complexe qui n’est pas toujours d’une grande lisibilité pour les entreprises.

Septembre 2023 | Aujourd’hui en France, 11 millions de personnes apportent de l’aide à un proche en perte d’autonomie : grand-parent, parent, enfant, proche…. Et surtout, plus d’un aidant sur deux est en activité. Que vous soyez aidant.e ou pas, votre voix en tant qu’entreprise/organisation compte ! Pour explorer cette thématique et ses enjeux pour les salariés et les organisations, les équipes santé...

Septembre 2023 | Mazars et l'EPRA vous présentent le Global REIT Survey France 2023.

Septembre 2023 | Mazars publie son 13ème baromètre des pratiques et tendances en matière de reporting extra-financier en France. Pour mener à bien cette étude, les documents de référence de plus de 70 sociétés du CAC 40 et du SBF 120 (DPEF et URD 2022) ont été analysés et comparés.

Forvis Mazars met à votre disposition une série de cahiers techniques et d'études pour vous permettre à la fois de maîtriser et mettre en œuvre les normes internationales d'information financière (IFRS), mais également d'apprécier les pratiques des grands groupes cotés sur des sujets clés.

En France, le secteur de l’immobilier figure parmi les industries les plus émettrices de gaz à effet de serre. Situé en quatrième position derrière le transport routier, l’agriculture et l’industrie manufacturière, et devant l’industrie de l’énergie et le traitement des déchets, le bâtiment émettrait 17 % des gaz à effet de serre, d’après le Haut Conseil pour le Climat, dans son rapport annuel de...

Juillet 2023 | Dans un souci croissant de transparence vis-à-vis du marché, la Directive Solvabilité II prévoit la publication annuelle d’un rapport sur la solvabilité et la situation financière (SFCR) à destination du public dont le contenu doit porter sur l’activité de l’assureur, son système de gouvernance, son profil de risque ainsi que sur des informations relatives aux méthodes de valorisation...

Découvrez dès aujourd’hui les résultats de l’enquête annuelle internationale “The State of Automation in Finance 2023 de Yooz, réalisée auprès de plus de 1500 directeurs financiers, sponsorisée par Mazars et la DFCG.

En marge de la première application d’IFRS 17, les principaux assureurs et réassureurs européens lèvent progressivement le voile sur le nouveau contenu de leur communication financière et les indicateurs au cœur des messages sur leurs activités.

Juin 2023 | L’année 2022 se termine avec un montant d’investissement de 26 milliards d’euros, quasi stable par rapport à 2021, mais avec des différences marquées selon les classes d’actifs. Les bureaux restent la catégorie d’actifs privilégiée des investisseurs en atteignant 14 milliards d’euros mais représentent désormais seulement 54% des volumes, contre les deux tiers habituellement, en raison...

Juillet 2023 | Comment l'ERP contribue-t-il à la transformation digitale des entreprises ? Bien que 52 % des entreprises françaises utilisent encore des progiciels de gestion intégrés datant de plus de 10 ans, le domaine des ERP peut sembler dépassé à première vue, mis à mal par la montée en puissance de la digitalisation et de l'intelligence artificielle, l'essor des algorithmes et l'émergence des...

Juin 2023 | Les nouvelles formes de contrats d’achat d’électricité peuvent-elles accélérer le déploiement des énergies renouvelables ? Les Corporate Power Purchase Agreements (PPA) sont des contrats d'achat d'électricité utilisés principalement par les entreprises pour s'approvisionner en électricité verte. Ces accords jouent un rôle essentiel dans la transition énergétique en favorisant le déploiement...

Juillet 2023 | Les projets d’intégration sont par nature source de réflexion, d’échanges et d’espoir d’amélioration. Comment appréhender et réussir les projets d’intégration en mobilisant les équipes des deux entités, et permettre à chaque collaborateur de comprendre et d’adhérer au mieux aux changements induits et inéluctables ?

Mars 2023 | Mazars et Estimeo dévoilent la deuxième édition de leur baromètre trimestriel de Confiance des startups, qui a pour objectif de mettre en lumière l’Indice de Confiance des Dirigeants de Startups.

Mars 2023 | Comme le montre notre dernier baromètre C-level, les dirigeants d'entreprise font part d’un état d'esprit combatif et d’une vision positive pour 2023, sans pour autant renier les défis importants de l'année écoulée, notamment l'inflation et l'instabilité économique, les prix élevés de l'énergie, les guerres et les tensions géopolitiques. Pour les trois à cinq prochaines années, la technologie...

Mars 2023 | Le début de l'année 2022 a été marqué par l'invasion de l'Ukraine par la Russie le 24 février, ce qui a donné le signal d'une année turbulente pour les marchés européens et mondiaux. Les tendances qui étaient déjà à l'œuvre en 2021, à savoir la hausse de l'inflation et des coûts d'emprunt, ont été fortement amplifiées. La guerre a déclenché des chocs d'approvisionnement, notamment sur...

Février 2023 | Les impôts sur la production sont un sujet éminemment d’actualité, l’annonce de l’allégement puis de la suppression de la cotisation sur la valeur ajoutée (CVAE) en France l’illustre. Ils restent malgré tout bien plus élevés dans l’hexagone que dans le reste des pays de l’Union européenne et peuvent ainsi constituer un frein pour la compétitivité économique française.

Février 2023 | Le crowdfunding immobilier obligataire constitue la locomotive du financement participatif en France et pèse pour un peu plus des 2/3 de la collecte globale.

Février 2023 | Pour la 4ème année consécutive, Mazars et l’association Financement Participatif France (FPF) publient le baromètre de référence du crowdfunding en France. Ce baromètre fait état du dynamisme d'un secteur au service d'une économie de proximité et de projets qui font sens.

Mazars en collaboration avec l’ASPIM a mené une étude comparative sur les indicateurs clés liés à la performance, aux risques et aux stratégies suivies par les FIA immobiliers « grand public ». Cette étude a été réalisée à partir d’un panel de 37 sociétés de gestion de portefeuille immobilières et sur la base de la communication financière publiée en 2022 par les trois catégories de FIA immobiliers...

Un focus sur les pertes de crédit attendues (Expected Credit Losses - ECL) dans un contexte d’incertitudes macroéconomiques persistant

Janvier 2022 | Les obligations réglementaires et les bonnes pratiques de gouvernance au sein des établissements financiers évoluent constamment. Cette étude vise à rappeler le cadre réglementaire, les bonnes pratiques applicables en matière de gouvernance, ainsi qu'à présenter un benchmark de la composition et du fonctionnement des principaux organes décisionnels au sein des établissements financiers.

Décembre 2022 | Mazars, Credit Safe, CNA et Jaggaer accompagnés par la chaire "Achats et Innovation Digitale" d'Audencia, avec l’appui d’un comité scientifique de plus de 20 directeurs Achats de premier plan, publient la première édition d’un baromètre qui vient mesurer la maturité des directions Achats en matière d’ESG, interroger leurs freins, motivations et axes d’améliorations et de transformation....

Novembre 2022 | Mazars publie sa première étude des pratiques et tendances en matière de reporting financier sur les enjeux climatiques. Pour mener à bien cette étude, les états financiers de près de 80 sociétés françaises et européennes ont été analysés et comparés.

Octobre 2022 | Mazars et Estimeo publient leur premier Baromètre de Confiance des Startups en France. Un baromètre qui a pour objectif de mettre en lumière l’Indice de Confiance des Dirigeants de Startups, initié par Mazars et Estimeo.

Octobre 2022 | La corruption est fréquemment abordée dans les médias, mais rarement dans les enquêtes d'opinion pour savoir ce qu'en pensent réellement les Français. Mazars a mené en partenariat avec l'Institut de sondage CSA une étude sur la perception par les Français de la corruption, tant dans le monde de l'entreprise privée que dans le secteur public. Pour comprendre comment la corruption est...

Décembre 2022 | Nous vous proposons dans cette étude un regard croisé entre les éclairages de l'équipe Ethique et Compliance de Mazars, au travers de l'interprétation des textes de la loi Sapin 2, des recommandations de l'Agence Française Anticorruption (AFA) et les retours d'expérience et meilleures pratiques en matière de digitalisation et de traitement des données liées aux enjeux de conformité...

Mazars publie son 12ème baromètre des pratiques et tendances en matière de reporting extra-financier en France. Pour mener à bien cette étude, les documents de référence de 70 sociétés du CAC 40 et du SBF 120 (DPEF et URD 2021) ont été analysés et comparés.

Septembre 2022 | Après une année 2020 marquée par la crise sanitaire de la Covid-19, les acteurs du BTP, de l’énergie, de l’immobilier et des concessions ont renoué avec la croissance sur cette année 2021, avec un niveau d’activité d’avant crise retrouvé, voire dépassé pour le secteur des Energies. Le taux de marge 2021 n’a cependant pas retrouvé le niveau de 2019, alors que le secteur doit affronter...

Juillet 2022 | Les cyber menaces nous entourent tous. Ce n'est pas de la paranoïa, c'est une triste réalité : chaque jour apporte de nouveaux piratages, de nouvelles fuites de données, de nouveaux embarras - et de nouveaux coûts, tant financiers que commerciaux. Personne n'est épargné. Les attaques visent les entreprises, grandes et petites, ainsi que les institutions du secteur public et les particuliers....

Juin 2022 | Après plus de deux ans de crise sanitaire et d’incertitudes liées au COVID-19, la nécessité de disposer d’un bon outil de pilotage de la performance et de contrôle de gestion semble plus forte que jamais. Mazars, qui accompagne ses clients dans leur schéma de pilotage de la performance, a cherché à savoir si les solutions actuelles du marché, à savoir les outils EPM, répondent aux besoins...

Juin 2022 | Nous avons analysé les rapports annuels 2021 de 26 banques dans 11 pays européens afin de mieux comprendre l'impact de la Covid-19 sur les pertes de crédit attendues et comment aider les banques à se préparer alors qu'elles font face à de nouveaux défis en raison du conflit en Ukraine. Cette étude est la quatrième de sa série et fait suite à notre troisième édition du rapport publiée en...

Juin 2022 | Mazars a mené une étude en partenariat avec l’institut de sondage CSA pour comprendre comment sont perçus les projets de réorganisation des entreprises (publiques ou privées) par les Français salariés, tout en les mettant en perspective avec la vision des dirigeants et la situation économique actuelle.

Juin 2022 | L’année 2021 pour les foncières européennes reste un exercice marqué par la crise Covid. Le volume d’investissement présente une baisse de 10% par rapport à 2020 même si celui-ci reste proche de la moyenne décennale avec environ 25 milliards d’euros investis. Les bureaux restent la classe d’actifs privilégiée des investisseurs, totalisant plus de 15 milliards d’euros investis. La logistique...

Mai 2022 | L'Amérique est un vaste continent souvent qualifié de "continent des contrastes" en raison de sa diversité naturelle, économique, culturelle et démographique. En outre, il présente également des inégalités en matière de structure économique et de développement. Ces facteurs créent une source d'incertitudes fiscales. Faire des affaires dans cette région peut être un défi en raison d'environnements...

Mai 2022 | Que l’on soit employé ou employeur, impossible d’ignorer l’actuel bouleversement des modes de travail, dont les contours se dessinent comme étant de plus en plus spécifiques à chaque entreprise, ce qui n’en simplifie pas la compréhension générale. Un trait commun se dégage déjà : la transformation passe par l’adaptation des lieux physiques du travail, avec l’arrivée massive du numérique,...

Décembre 2022 | Le cahier technique « IFRS 16 : l’essentiel de la norme sur les contrats de location, en 80 questions / réponses » rassemble et présente de manière pédagogique l’ensemble des connaissances nécessaires à la comptabilisation des contrats de location.

Mai 2022 | Mazars a mené en partenariat avec l’Institut de sondage CSA une étude sur la notoriété et l’image des algorithmes d’intelligence artificielle (IA) auprès du grand public.

Mai 2022 | L’immobilier sanitaire, médico-social et social figure parmi les premiers patrimoines bâtis de France avec environ 75 millions de m² pour les structures hospitalières et 30 à 40 millions de m² pour les établissements médico-sociaux. Les questions immobilières sont de plus en plus au cœur des préoccupations des pouvoirs publics et des gestionnaires médico-sociaux et sanitaires. Cette nouvelle...

Mars 2022 | Les experts santé de Mazars vous proposent des entretiens avec plusieurs acteurs qui contribuent à la transformation de l’offre médico-sociale pour les personnes âgées.

Mars 2022 | À la fin de l'année 2021, notre baromètre C-level montrait que les entreprises sortaient de la pandémie avec un sentiment de confiance et de résilience. Elles avaient confiance en leur capacité à répondre aux défis à venir, et prévoyaient en même temps de transformer leurs activités et d'investir. Désormais, l'ESG figure en bonne place dans l'agenda des C-level et, en parallèle, les entreprises...

Mars 2022 | Le recours à l’Agilité n’est plus une question pour la grande majorité des Directions des Systèmes d’Information (DSI) qui pratiquent ces méthodes sur tout ou partie de leur périmètre. La question qui se pose désormais est la manière dont cette agilité devient partie intégrante du fonctionnement de l’entreprise.

Avril 2022 | Des structures de planification fiscale particulièrement sophistiquées affectent fortement la capacité des États à protéger leur base d'imposition de l'érosion, avec pour conséquence une diminution considérable des recettes fiscales. La directive DAC6 s’inscrit dans un mouvement global de développement des outils juridiques à destination des États afin de faciliter la coopération en matière...

Février 2022 | En 2020, les impôts de production étaient en moyenne au moins deux fois plus élevés en France que dans le reste des pays de l’Union européenne. Ils constituent un véritable frein pour la compétitivité économique française.

Février 2022 | Les bénéfices de la diversité ne sont plus à prouver. Pourtant, force est de constater que les inégalités liées au genre persistent, en particulier dans les comités exécutifs et parmi les PDG. Cette publication, « Les mythes et barrières qui freinent les carrières des femmes : décryptage et solutions », développée par Mazars en partenariat avec l’Observatoire de la Mixité, s’adresse...

Qualitadd et Mazars publient une enquête réalisée au sein de sociétés du secteur de l’assurance afin d’attester de l’accélération de la transformation digitale des organisations depuis la crise sanitaire liée au Covid-19. Cette étude vise à fournir un état des lieux des évolutions réalisées en peu de temps pour participer à la transformation profonde des organisations répondantes mais également les...

Pour la 3ème année consécutive, Mazars et l’association Financement Participatif France (FPF) publient le baromètre de référence du crowdfunding en France. Ce baromètre fait état du dynamisme d'un secteur qui s'inscrit en véritable acteur du financement alternatif ou complémentaire.

Février - 2022 La santé est au cœur des préoccupations des Français. Régulièrement citée parmi les thématiques prioritaires des Français ces dernières années, elle a vu son importance encore accentuée à la faveur du COVID-19, en devenant même la priorité n°1. La santé constitue également un axe essentiel et stratégique de l’action publique. En France, 12% de la dépense publique lui est consacrée et...

Ces dernières années, l’évolution de la communication extra-financière a été importante, nourrie par de nouvelles demandes obligatoires, imposant une information plus abondante pour les principaux acteurs. Qu’il s’agisse de la Taxonomie Verte ou de la nouvelle directive CSRD, les entreprises vont devoir intégrer très rapidement ces ambitions et ces nouveaux textes qui pourront impacter non seulement...

Janvier - 2022 Alors que les travaux de la Haute Autorité de Santé concernant la réforme des dispositifs d’évaluation des établissements et services médico-sociaux sont en cours de finalisation, le nouveau format d’évaluation intégrera notamment les outils qualité suivants : l’audit de processus, l’audit système et l’usager traceur. Pour en savoir plus, les équipes Santé de Mazars sont allées à la...

Après une météo orageuse depuis le début de la crise sanitaire, quelques éclaircies sont apparues en 2021 avec notamment la montée en puissance du label ISR qui démontre une préoccupation de plus en plus forte des politiques d’investissement des fonds immobiliers sur les critères ESG. Dans cet environnement en constante mutation, quels sont les indicateurs clés et bonnes pratiques appliqués dans la...

Le marché de la consommation chinoise, classé en seconde position après les États-Unis, est essentiel pour les marques nationales et internationales. Alors que les comportements d'achat des consommateurs en Chine ont été bien documentés, les changements plus récents concernant les préférences des consommateurs liés à la Covid-19, sont moins bien connus. Notre étude montre que les tendances de comportement...

Les institutions financières reconnaissent que le changement climatique et les autres risques environnementaux, sociaux et de gouvernance d'entreprise mettent en péril l'économie et le système financier mondiaux. La pandémie de Covid-19 a souligné l'importance de la résilience des systèmes financiers. Les banques du monde entier reconnaissent qu'elles ont un rôle clé à jouer dans la transition vers...

Décembre - 2021 L’intelligence artificielle porte la promesse de révolutionner le secteur de la santé, par un renforcement de la qualité des soins et une plus grande efficience. Le plan Innovation Santé 2030 annoncé en juin 2021 comporte d’ailleurs un volet spécifique dédié à l’intelligence artificielle. Cependant, la collecte, le traitement et la fiabilité des données nécessaires aux algorithmes...

Décembre - 2021 Grâce à sa place en Europe et à son intégration dans l'UE, l'Europe occidentale tend à être moins source d'incertitudes fiscales. Cependant, mener des affaires dans cette région peut être un défi au regard d'environnements fiscaux peu similaires.
Êtes-vous aussi avancés que vous le pensez ? Avec une utilisation de plus en plus importante de la donnée par les organisations, Mazars et DataGalaxy ont souhaité faire un état des lieux de la maturité des organisations vis-à-vis de la gouvernance des données. Basée sur un échantillon de plus de 1100 experts data seniors de différents secteurs d’entreprises dans 21 pays, notre étude Global Data 2021...

Dix-huit mois après le début de la crise sanitaire, comment se portent les ETI (entreprises de taille intermédiaire) ? Dans quel état d’esprit se trouvent leurs dirigeants ? Comment les ETI se sont-elles financées durant la crise et à quelles sources de financement s’intéressent-elles de plus en plus ?

2022 | Improbable hier, nécessaire aujourd'hui, la réinvention de l'audit est sur le point de marquer un tournant dans l'histoire de la profession. Découvrez notre programme dédié à l'avenir de l'audit : Reinventing Audit.

Comment la Covid-19 a-t-elle affecté les résultats semestriels 2021 des banques européennes ? Cette étude analyse les rapports semestriels 2021 d'un panel de 26 banques issus de 11 pays européens afin de suivre l'impact de la Covid-19 sur les pertes de crédit attendues ou Expected Credit Loss (ECL). Cette édition est la troisième de sa série et fait suite aux études réalisées sur le 30 juin 2020 et...

La finance à impact connait un développement important depuis l’Accord de Paris sur le climat. La Place de Paris s’évertue à construire une expertise cohérente et solide avec un leadership assumé mais il reste encore du travail pour aboutir à un consensus dans les pratiques observées. Dans le contexte de la COP26, l’AFG et Mazars publient une grande étude sur la finance à impact pour mesurer le niveau...

Mazars publie la deuxième édition de son enquête consacrée aux Français et l'assurance de demain réalisée avec OpinionWay. Quelle relation les Français ont-ils avec leur assureur ? Quelle est leur perception de leur couverture et leur disposition à l'égard de nouveaux services ? Qu'attendent-ils de leur assureur en matière d'engagement RSE ? Telles sont les questions qui ont été analysées et synthétisées...

Bien que la conformité soit depuis longtemps un élément important dans la prise de décisions stratégiques des entreprises et un des fondements d'une croissance continue, elle peut encore être perçue comme une simple obligation, plutôt que comme une opportunité.

Octobre - 2021 La fiscalité environnementale constitue un droit émergent en phase avec les préoccupations économiques et sociales actuelles. Face aux nombreuses normes en vigueur, les entreprises, comme les particuliers, doivent apprendre à maîtriser cette fiscalité en construction.

Découvrez les enjeux de la data dans notre livre blanc "Odyssée dans la Data"

Octobre 2021 En pleine crise des prix de l’énergie et à quelques mois de la COP 26, il n’a jamais été autant question de l’énergie trilemma, c’est-à-dire la fourniture d’une énergie bas carbone, bon marché et sans coupure. Une technologie se distingue : Le Small Modular Reactor (SMR). La communauté Mazars Énergie et Environnement, vous présente les grands enjeux de la filière SMR.

L’Autorité de Contrôle Prudentiel et de Résolution (ACPR) a réalisé en 2020 un exercice pilote en s’appuyant sur les recommandations et les travaux du réseau des banques centrales, ainsi que des superviseurs pour le verdissement du système financier (NGFS). Il s’agit d’un exercice exploratoire conçu avec les équipes de la Banque de France visant à évaluer les risques associés au changement climatique.

Le pôle Corporate d’EthiFinance, associé à Mazars en France, a souhaité prendre la mesure de l’évolution des pratiques sur le marché européen des obligations vertes et durables à la lumière des recommandations de l’ICMA.

Mazars publie son 11ème baromètre des pratiques et tendances en matière de reporting extra-financier en France. Pour mener à bien cette étude, les documents de référence de 70 sociétés du CAC 40, du Next 25 et du Last 15 du SBF 120 ont été analysés et comparés.

Au cours des dernières années, la finance quantitative est devenue un domaine d'application privilégié de la data science. L’accroissement de la puissance de calcul des ordinateurs, le développement du deep learning, ainsi que le volume croissant des données disponibles ont rendu possible l'application d'algorithmes plus complexes et plus performants issus de ce domaine. La détection d'anomalies et...

La pandémie de la COVID-19 aura profondément bouleversé les activités économiques, rythmées par les mesures de confinement et la fermeture des commerces non essentiels. Dans ce contexte, le marché de l’assurance a été relativement préservé. Si certaines branches d’activité ont été fortement touchées, comme les garanties pertes d’exploitation et arrêts de travail, d’autres branches ont connu une amélioration...

Malgré les incertitudes liées à la crise et l’essor du télétravail, les bureaux restent la classe d’actifs privilégiée par les investisseurs qui affichent néanmoins une certaine prudence en privilégiant les produits les plus sécurisés. Le marché de la logistique a été le marché très actif en 2020 avec des valeurs à la hausse poussées par les besoins du e-commerce alors que sans surprise le commerce...

Nos experts se sont interrogés dans cette nouvelle édition sur la manière dont les majors européens du BTP ont traversé cette crise sanitaire de la Covid-19 démarrée en mars 2020. Afin d’analyser la performance du secteur dans ce contexte particulier, cette étude compare les résultats annuels 2020 des majors européens du BTP, et détaille les résultats par secteur d’activité, permettant de mettre en...

L’information extra-financière s’invite désormais dans tous les aspects de la vie de l’entreprise, et touche à autant d’enjeux qui sont au cœur des missions des administrateurs et des conseils d'administration.

Pour de nombreuses entreprises, la recherche d'opportunités en dehors de leur pays d'origine fait partie intégrante du processus de croissance. En s'ouvrant à de nouveaux marchés et en se connectant à de nouveaux clients, les entreprises peuvent augmenter leurs ventes et leurs bénéfices, tout en répartissant leurs risques en ne dépendant pas d'un seul marché.

Le Règlement Général sur la Protection des Données (RGPD) est en vigueur depuis le 25 mai 2018, soit depuis plus de 3 ans. Conscient de ces nouveaux défis et de leur sensibilité pour les entités financières, Mazars vous propose cette étude ayant pour objectif d’analyser l’évolution des sanctions rendues par la CNIL afin d’en tirer des enseignements opérationnels pour le secteur bancaire.

Dirigeants d'entreprise, les Français sont prêts à construire le monde de demain avec vous.

Comment la pandémie affecte-t-elle la performance financière des banques européennes ? La crise de la Covid-19 continue de nuire à la stabilité financière mondiale. Bien que son impact total sur le secteur bancaire reste à déterminer, les résultats annuels 2020 nous permettent de dresser un tableau de l’impact de la Covid-19 sur les Expected Credit Loss (ECL) issus des informations financières des...

Avril 2021 | Quelles sont les attentes, en matière d'audit, des Directeurs financiers et Présidents de Comité d'audit de grandes entreprises, dans le contexte spécifique de la France ?

Malgré les difficultés causées par la pandémie de Covid-19, les opérations de fusions et acquisitions en Europe centrale et orientale sont restées soutenues en 2020. Grâce à ses solides fondamentaux, la région des PECO a continué d'attirer les investissements internationaux, s'en sortant plutôt bien par rapport aux autres marchés émergents. Cette publication offre une vue d'ensemble de l'activité...

Objectif neutralité carbone à horizon 2050 : Mazars publie les résultats d’une étude exclusive menée fin 2020 en partenariat avec l’IFOP auprès de plus de 400 dirigeants d’entreprises françaises (de la TPE jusqu’au groupe côté) sur leur rapport à la neutralité carbone.

La loi Pacte, novatrice et incitative, pose les fondements juridiques de la responsabilité sociétale des entreprises. Elle est l'opportunité pour elles de valoriser et dynamiser leurs engagements sociaux et environnementaux au plus haut niveau, en tant qu'acteurs majeurs et moteurs des transitions nécessaires

Février - 2021 En septembre 2020, la Haute Autorité de Santé (HAS) publiait la recommandation « Soutenir et encourager l'engagement des usagers dans les secteurs social, médico-social et sanitaire » à destination des établissements qui souhaitent démarrer ou accélérer leurs démarches Expérience Usagers.

Face aux grands bouleversements économiques et sociétaux causés par la pandémie du Covid-19, les acteurs majeurs du secteur financier continuent de prendre en considération la durabilité environnementale et de reconnaître les risques et les opportunités qui en découlent, tant pour le marché que pour les actionnaires et les autres acteurs du secteur. Le deuxième benchmark de Mazars sur les pratiques...

De l'optimisme malgré un environnement incertain

Pour la 2ème année consécutive, Mazars et l’association Financement Participatif France (FPF) publient le baromètre de référence du financement participatif en France. Ce baromètre se fait l’écho de la vitalité et de la diversité des modes d’intervention du crowdfunding.

Mazars lance la 1ère édition de son baromètre « C-level ». Ce dernier recueille la vision des cadres dirigeants du monde entier sur leurs activités, ainsi que leurs perspectives pour l'année à venir afin de comprendre leur gestion de la crise sanitaire.

Retrouvez dans cet entretien, l’analyse de Veruschka Becquart sur les enjeux de la mobilité durable et les projections d’avenir pour le marché des VTC.

La RSE a pris une place prépondérante dans le paysage économique. Dans les Universal Registration Document (URD) tout d’abord, où initialement en fin de document, les informations de ces publications ont fait une remontée vers les premiers chapitres. Dans le cadre des Assemblées Générales ou encore lors de la présentation des résultats annuels, où les indicateurs extra-financiers sont de plus en plus...

Janvier - 2021 Entretiens croisés avec l’ADAPEI de l’Eure, la Fondation Britannique de Sillery et l’Etablissement Public Autonome Helen Keller, acteurs qui contribuent à la transformation de l’offre médico-sociale pour les personnes en situation de handicap.

Après une année de collecte record en 2019, les gestionnaires de fonds immobiliers doivent faire face à des perturbations majeures dans un contexte complétement inédit lié à la pandémie. Comment la communication financière des SCPI et OPCI répond-elle à cette situation inédite ?

Doing M&A in CEE: Tax traps and structuring opportunities Dans un contexte de concurrence mondiale et de marchés intégrés, de nombreuses entreprises recherchent des opportunités de croissance en dehors de leur pays d'origine, malgré des environnements réglementaires changeants et parfois complexes....

L’année 2020 fut une année marquante pour les acteurs du Private Equity à bien des égards. Si la crise Covid-19 a pu sérieusement impacter, à la hausse mais surtout à la baisse, les fondamentaux des participations de leur portefeuille, les sociétés de gestion ont dû faire face à un questionnement permanent sur la manière de retranscrire les impacts de cette crise sur l’évaluation de leurs actifs.

Mazars publie une étude sur l’information financière au 30 juin 2020 des sociétés de l’Eurostoxx50 dans la tourmente de la crise sanitaire.

Le secteur du luxe a toujours été soucieux d'offrir aux consommateurs la possibilité d'acquérir des pièces intemporelles dont la valeur et la beauté perdureront dans le temps. Mais cela ne signifie pas que la façon dont il les produit et les vend doit également rester la même. L'industrie du luxe est à la croisée des chemins et les marques, qui continuent à faire ce qu'elles ont fait depuis toujours,...

Nos équipes ont analysé les décisions publiques de la Commission des sanctions de 2017 à 2019 de façon à identifier les thématiques récurrentes en matière de LCB/FT, ainsi que les exigences réglementaires que les établissements peinent parfois à appliquer de façon opérationnelle. Elles constituent un corpus de règles pragmatiques de cas concrets qui viennent compléter la réglementation existante....

Mazars, architecte 360° de vos futures solutions finance et performance, et Uipath, ont mené une enquête auprès des fonctions finance, ressources humaines et DSI afin de faire un état des lieux de la tendance du marché et d'évaluer la maturité des acteurs sur l'utilisation de la RPA au sein des entreprises. L'enquête a été menée auprès de 501 personnes issues du panel Yougov en France.

Afin d’analyser la gestion de la crise de la Covid-19 par les acteurs français du BTP, nos experts présentent dans cette étude un comparatif des résultats semestriels des majors du BTP français et européens. Cette étude met en évidence que les acteurs français sont plus pénalisés que leurs concurrents européens, puis présente la communication des majors et des autres groupes français sur la gestion...

L'analyse des données aide les entreprises de transport à améliorer leurs opérations commerciales. Elle leur permet de prendre de meilleures décisions basées sur des connaissances complètes et actuelles des KPI qui les concernent. Dans un secteur où les marges sont faibles et volatiles, il est crucial de pouvoir regrouper toutes les données de façon à mieux les connaître et mieux les comprendre. Pourtant,...

Décryptage d'un cadre réglementaire en constante évolution, pour réguler l’empreinte carbone et « verdir » l'industrie automobile. Depuis quelques années, la filière opère sa transformation vers le véhicule «vert» et se joint ainsi à l’action des pouvoirs publics pour : agir pour le climat, préparer l’après-pétrole, s’engager pour la croissance verte et financer la transition énergétique.

Alors que la crise du COVID-19 a invité le secteur médico-social à se réinventer en encourageant de nouveaux usages numériques et après l’annonce d’un plan d'investissement de 600 M€ sur cinq ans lors du Ségur de la Santé, les équipes Mazars Santé ont souhaité s’entretenir avec ceux qui vivent et accompagnent ces transformations à l’échelon national.

Nos experts conseil Financial Services se sont intéressés au plan d'action de la Commission européenne sur la Finance Durable. Cette étude met en avant d'une part, le contexte et le contenu du plan d'action et d'autre part, les objectifs et impacts de cette réglementation.

En juin 2020, l'IASB a publié le texte définitif de la norme et amendements à la norme IFRS 17, ainsi que les amendements à IFRS 4 portant sur le différé de la norme IFRS 9. Dans le cadre de cette étude, nos experts se sont penchés sur les changements et les impacts issus de ces dernières évolutions.

Depuis le début de la crise sanitaire sans précédent que nous traversons, les départements Immobilier, en lien avec l’ensemble des fonctions supports et opérationnelles, contribuent fortement à l’adaptation des modes de fonctionnement de leurs organisations, afin d’assurer une continuité d’activité pour limiter l’impact de la pandémie, et mettre en place les conditions d’une reprise la plus dynamique...

La crise du Covid-19 aura un impact financier sur les opérations de prêt et pourrait même entraîner des pertes au sein des banques pour l'année fiscale 2020. Au-delà des impacts financiers et règlementaires, les pratiques et méthodes antérieures en matière de prix de transfert pourraient ne pas être applicables en 2020. Dès lors, aux vues des circonstances actuelles, les banques devront déterminer...

Mazars publie son 10ème baromètre des pratiques et tendances en matière de reporting extra-financier en France. Pour mener à bien cette étude, les documents de référence de 67 sociétés du CAC 40, du Next 25 et du Last 15 du SBF 120 ont été analysés et comparés.

Dans le cadre de cette étude, nos experts se sont intéressés aux enjeux et impacts de la crise de la COVID-19 pour les principaux assureurs et réassureurs européens. Pour ce faire, nos équipes ont analysé la communication financière au 30 juin 2020 d’un panel représentatif du secteur au niveau français et européen.
Ce site web utilise des cookies.
Certains de ces cookies sont nécessaires, tandis que d'autres nous aident à analyser notre trafic, à diffuser de la publicité et à offrir des expériences personnalisées pour vous.
Pour plus d'informations sur les cookies que nous utilisons, veuillez vous référer à notre politique de confidentialité.
Ce site web ne peut pas fonctionner correctement sans ces cookies.
Les cookies analytiques nous aident à améliorer notre site web en collectant des informations sur son utilisation.
Nous utilisons des cookies marketing pour améliorer la pertinence de nos campagnes publicitaires.
